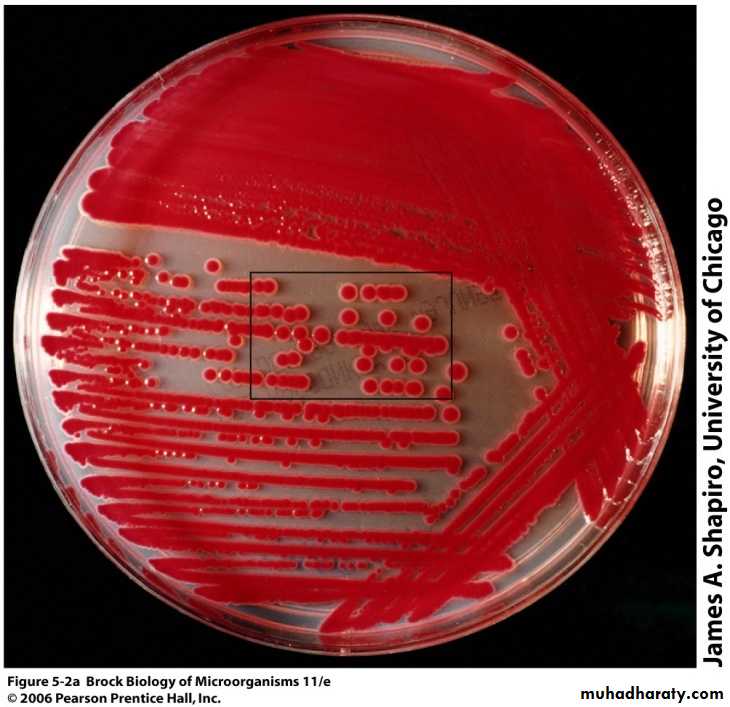

Microbial Growth and Nutrition
Microbial GrowthMicrobial growth = increase in number of cells, not cell size
Microbial Growth
Microbes grow via binary fission, resulting in exponential increases in numbersThe number of cells arising from a single cell is 2n after n generations
Generation time is the time it takes for a single cell to grow and divide
Microbial Growth: Growth Curve
lag phase: no growth and microorganisms are making macromolecules in preparation for growthlog phase cultures are growing maximally
Stationary phase occurs when nutrients are depleted and wastes accumulate (Growth rate = death rate)
Death phase death rate is greater than growth rate
Temperature
pHOsmotic pressure
Oxygen classes
Environmental Factors Affecting Microbial Growth
Environmental Factors : Temperature
Temperature is a major environmental factor controlling microbial growth.. Minimum growth temperature: Temperature below which growth ceases, or lowest temperature at which microbes will grow.
. Optimum growth temperature: Temperature at which the microbial growth rate is the fastest.
. Maximum growth temperature: Temperature above which growth ceases, or highest temperature at which microbes will grow.
Classification of Microorganisms by Temperature Requirements
. Psychrophiles : Cold temperature optima (grow between -10-20oC).
• . Psychrotrophs: Cold temperature optima (grow between 0-30oC).. Mesophiles ( 20 – 45 C)
Midrange temperature optima (neither too hot nor too cold, typically between 20 and 45 °C). Found in warm-blooded animals
. Thermophiles ( 50- 80 C)
Growth temperature optima between 45ºC and 80ºC
. Hyperthermophiles
Optima greater than 80°C
These organisms inhabit hot environments including boiling hot springs, as well as undersea hydrothermal vents that can have temperatures in excess of 100ºC
Environmental Factors : Temperature
pH
Most bacteria grow between pH 6.5 and 7.5 (neutrophiles)Molds and yeasts grow between pH 5 and 6
Acidophiles grow in extreme acidic environments (less than 2) such as Helicobacter pylori
Alkaliphiles grow best at high pH medium such as Vibrio cholera that can tolerate pH medium up to 9.5
Environmental Factors : pH
Environmental Factors: Osmotic pressure• organisms which thrive in high solute – osmophiles
• organisms which tolerate high solute – osmotolerant
• organisms which thrive in high salt – halophiles
• organisms which tolerate high salt – halotolerant
• . Xerophiles : are able to grow in very dry environments
Environmental Factors: Osmotic pressure
• Osmotic Pressure• Hypertonic environments, increase salt or sugar, cause plasmolysis
• Extreme or obligate halophiles require high osmotic pressure
• Facultative halophiles tolerate high osmotic pressure
Environmental Factors: Oxygen
. Obligate (strict) aerobes require O2 in order to grow. Facultative anaerobes grow better in O2
. Obligate (strict) anaerobes cannot survive in O2
. Aerotolerant organisms don’t care about O2
. Microaerophiles require low levels of O2
obligate aerobes
Faultative anaerobes
Obligate anaerobes
Aerotolerant
Microaerophiles
Classification of organisms based on O2 utilization
• Utilization of O2 during metabolism yields toxic by-products including singlet oxygen:(1O2), superoxide free radicals (O2), hydrogen peroxide (H2O2) and Hydroxyl radical(OH).
• Toxic O2 products can be converted to harmless substances if the organism has catalase (or peroxidase) and superoxide dismutase (SOD) enzymes.
Toxic Forms of Oxygen
Toxic Forms of Oxygen
. SOD converts O2- into H2O and O2. Catalase breaks down the H2O2
. Peroxidase converts H2O2 into H2O. In general any organism that can live or requires O2 has SOD and catalase (or peroxidase).
Reducing media
Contain chemicals (thioglycollate or oxyrase) that combine O2Provides aerobic and anaerobic conditions
Anaerobic Culture Methods
Anaerobic jar
Anaerobic Culture MethodsCandle jar
CO2-packetCapnophiles require high CO2
Microbial Nutrition
The hundreds of chemical compounds present inside a living cell are formed from nutrients.Macronutrients : elements required in fairly large amounts
Micronutrients : metals and organic compounds needed in very small amountsMain Macronutrients: Carbon
• Carbon (C), 50% of dry weight
• Structural organic molecules, energy source
• Autotrophs use CO2
• Chemoheterotrophs use organic carbon sources
Nitrogen, 12% of dry weight
In amino acids, proteinsMost bacteria decompose proteins
Most bacteria can use Ammonia – NH3 and many can use NO3-Nitrogen fixers can utilize atmospheric nitrogen (N2)
Main Macronutrients: NitrogenSulfur
In amino acids, thiamine, biotinMost bacteria decompose proteins
Some bacteria use SO42 or H2S
Phosphorus
In DNA, RNA, ATP, and membranes
PO43 is a source of phosphorus
• Phosphate, potassium (K), magnesium(Mg), calcium (Ca), sodium (Na) and iron(Fe).
Other Macronutrients• .Usually metals needed in very little amount but are critical to cell function
• . Usually as enzyme cofactors• . e.g. Nickel(Ni), selenium (Se), Tungsten ( W), copper (Cu), Cobalt (Co).
Micronutrients: Trace elements
Organic Growth Factors
Organic compounds obtained from the environment and needed in very small amount only by some cellsVitamins, amino acids, purines, pyrimidines
The Requirements for Growth: Growth FactorsCulture Medium: Medium containing nutrients that support microbial growth
Sterile: No living microbesInoculum: Introduction of microbes into medium
Culture: Microbes growing in/on culture medium
Culture Media
Types of Culture Media
Media can be classified on three primary levels:• Physical State
• Chemical Composition
• Functional type
Types of Culture Media: Physical State
• Liquid Media: Fluid in nature, usually placed in test tubes, for example nutrient broth.• Solid : Prepared by adding solidifying agents like gelatin and agar to the liquid medium, for example, nutrient agar.
• Solid :(can be converted into a liquid)
• Solid: (cannot be converted into a liquid)
• Semisolid
Types of Culture Media: Chemical Composition
• Synthetic Media• Complex or Non-synthetic Media
Contains at least one ingredient that is not chemically definable (extracts from plants and animals)
No exact formula / tend to be general and grow a wide variety of organisms
Culture Media: Chemical Composition
Synthetic Medium
Non-synthetic MediumCulture Media: Functional type
• Simple Medium: it contains only basic substance such as nitrogen , carbon and minerals that are essential for bacterial growth, .e.g.• nutrient broth,
• nutrient agar,
• peptone water
• Enriched Medium: Some nutritionally enriched material like blood, serum or asctic fluid is added to the medium, required for proper growth of some bacteria, .e.g.
• blood agar
• Chocolate agar
Culture Media: Functional type
• Differential Medium: it differentiates between two groups of bacteria, e.g.,• blood agar,
• MacConkey's Medium
• Selective Medium: In this media an inhibitory substance is added to the media which prevents growth of all organisms except the one for which it is designed. e.g.
• Lowenstein Jensen's medium
A pure culture contains only one species or strain
A colony is a population of cells arising from a single cell or spore or from a group of attached cells
A colony is often called a colony-forming unit (CFU)
Pure Culture
Plate Counts: Perform serial dilutions of a sample
Measurements of Microbial Growth: Plate countMeasurements of Microbial Growth: Microscopic count
. Need a microscope, special slides, high power objective lens.Typically only counting total microbe numbers
Differences in electrical conductivity between species
Fluorescence of some speciesCells selectively stained with antibody + fluorescent dye
Measurements of Microbial Growth: Flowcytometry